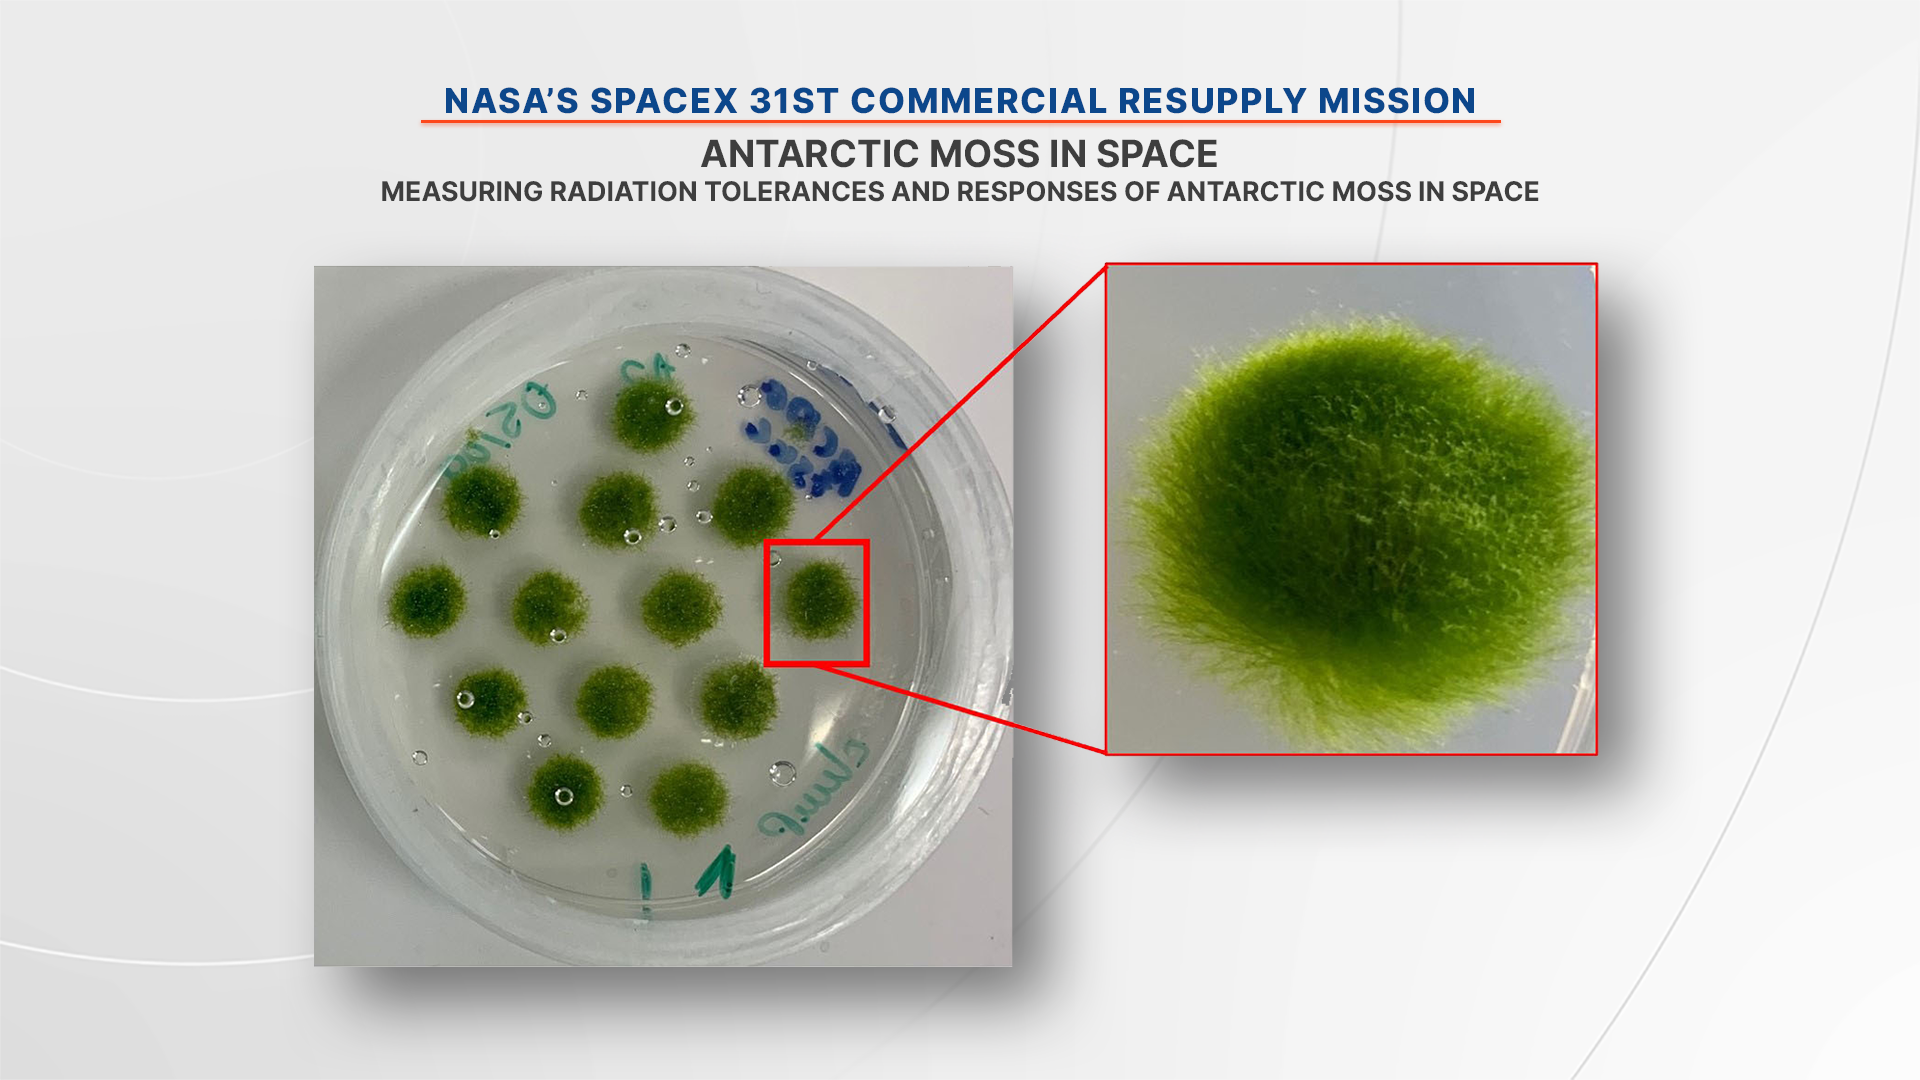

NASA and SpaceX are targeting no earlier than 9:29 p.m. EST on Monday, Nov. 4, for the next launch to deliver scientific investigations, supplies, and equipment to the International Space Station. Filled with more than 6,000 pounds of supplies, the SpaceX Dragon cargo spacecraft, on the company’s Falcon 9 rocket, will launch from Launch Complex 39A at NASA’s Kennedy Space Center in Florida.
This launch is the 31st SpaceX commercial resupply services mission to the orbital laboratory for the agency, and the 11th SpaceX launch under the Commercial Resupply Services-2 (CRS) contract. The first 20 launches were under the original resupply services contract.
NASA’s live launch coverage will begin at 9:10 p.m. on NASA+ and the agency’s website. Learn how to stream NASA content through a variety of platforms, including social media.
Arrival & Departure
The SpaceX Dragon spacecraft will arrive at the space station and dock autonomously to the forward port of the station’s Harmony module at approximately 10:15 a.m. on Tuesday, Nov. 5. NASA astronauts Butch Wilmore and Nick Hague will monitor the arrival of the spacecraft, which will stay docked to the orbiting laboratory for about one month before splashing down and returning critical science and hardware to teams on Earth.
Live coverage of arrival will begin at 8:45 a.m. Nov. 5 on NASA+ and the agency’s website. Learn how to stream NASA content through a variety of platforms, including social media.
Research Highlights
Scientific investigations traveling in the SpaceX Dragon spacecraft include studies of solar wind, a radiation-tolerant moss, spacecraft materials, and cold welding in space.
Measuring Solar Wind
The CODEX (COronal Diagnostic EXperiment) examines the solar wind, creating a globally comprehensive data to help scientists confirm theories for what heats the solar wind – which is a million degrees hotter than the Sun’s surface – and sends it streaming out at almost a million miles per hour.
The investigation uses a coronagraph, an instrument that blocks out direct sunlight to reveal details in the outer atmosphere or corona. The instrument takes multiple daily measurements that determine the temperature and speed of electrons in the solar wind, along with the density information gathered by traditional coronagraphs. A diverse international team has been designing, building, and testing the instrument since 2019 at NASA’s Goddard Space Flight Center in Greenbelt, Maryland.
Antarctic Moss in Space
A radiation tolerance experiment, ARTEMOSS, uses a live Antarctic moss, Ceratodon purpureus, to study how some plants better tolerate exposure to radiation and to examine the physical and genetic response of biological systems to the combination of cosmic radiation and microgravity. Little research has been done on how these two factors together affect plant physiology and performance, and results could help identify biological systems suitable for use in bioregenerative life support systems on future missions.
Mosses grow on every continent on Earth and have the highest radiation tolerance of any plant. Their small size, low maintenance, ability to absorb water from the air, and tolerance of harsh conditions make them suitable for spaceflight. NASA chose the Antarctic moss because that continent receives high levels of radiation from the Sun.
Exposing Materials to Space
The Euro Material Ageing investigation from the European Space Agency includes two experiments studying how certain materials age while exposed to space. The first experiment, developed by Centre National d’Etudes Spatiales, includes materials selected from 15 European entities. The second experiment looks at organic samples and their stability or degradation when exposed to ultraviolet radiation not filtered by Earth’s atmosphere.
Predicting the behavior and lifespan of materials used in space can be difficult because facilities on the ground cannot simultaneously test for all aspects of the space environment. The exposed samples are recovered and returned to Earth.
Repairing Spacecraft from the Inside
Nanolab Astrobeat investigates using cold welding to repair perforations in the outer shell or hull of a spacecraft from the inside. Less force is needed to fuse metallic materials in space than on Earth, and cold welding could be an effective way to repair spacecraft.
Some micrometeoroids and space debris traveling at high velocities could perforate the outer surfaces of spacecraft, possibly jeopardizing mission success or crew safety. The ability to repair impact damage from inside a spacecraft may be more efficient and safer for crew members. Results also could improve applications of cold welding on Earth as well.
Cargo Highlights
SpaceX’s Falcon 9 rocket will launch the company’s Dragon spacecraft to the International Space Station.
Hardware for Launch
Potable Water Dispenser Filter – The filter unit, installed into the potable water dispenser on the station, will provide the capability to remove iodine from the water before the crew consumes it in food and drink packages.
Reducer Cylinder Assembly & Emergency Portable Breathing Apparatus – Together, this hardware provides 15 minutes of oxygen to a crew member in case of an emergency (smoke, fire, alarm). Two are launching to maintain minimum in-orbit spare requirement.
Multifiltration Bed – Supporting the water processor assembly, this spare unit will continue the International Space Station program’s effort to replace a degraded fleet of units in orbit that improve water quality through a single bed.
Pump Package Assembly – A variable speed pump, reservoir, accumulator assembly used for circulating coolant through the internal active thermal control system loops. This assembly is being flown to maintain the minimum in-orbit spare requirement.
Microbial Removal Filter Cartridge Bag Assembly – Used with the microbial removal filter to offload stowed water to water tank, the assembly will operate under suction to pull water through the filter. These assemblies are replacing current systems that are expiring.
Advanced Restrictive Exercise Device Cable Arm Rope Assembly – Distributes exercise loads through a series of pulleys. The ropes have a limited life cycle, and it is necessary to replace ropes that have achieved their cycle-life limit. This unit is being launched as an in-orbit spare.
International Docking Adapter Planar Reflector Assembly – With an aluminum base and reflective element, visiting vehicles reflect a laser to compute relative range, velocity and attitude to the space station. The current unit is scheduled to be retrieved and replaced during an upcoming spacewalk.
Hardware for Return
Hydrogen Dome – includes all hydrogen and oxygen electrolysis components within the space station’s oxygen generation assembly. These items are contained in a sub-ambient dome maintained at near vacuum pressure, designed to contain an explosion or fire in the electrolysis cell stack during operation. The dome provides a second barrier to protect against cabin air internal leakage and external leakage into the rack environment and is pressurized with nitrogen gas for launch. The dome is returning for repair and re-flight.
Microgravity Experiment Research Locker Incubator Drawer – An aluminum temperature-controlled container designed to maintain conditions for scientific experiments and is returning for refurbishment and re-flight.
Catalytic Reactor – The catalytic reactor replacement unit oxidizes volatile organics from the wastewater so they can be removed by the gas separator and ion exchange bed replacement units as part of the station’s water recycling system. This unit failed in orbit and is being returned for analysis and refurbishment.
Ethylene Scrubber – This container removes ethylene, a plant-produced gas, from the plant growth chamber and helps keep vegetables fresh. This unit will return for refurbishment and re-flight.
Environmental Control System Module – An aluminum box that holds the environmental control system for the plant growth chamber. The environmental control system controls the humidity and other environmental factors within the plant habitat. This module is returning for refurbishment and re-flight.
Ion Exchange Bed – The ion exchange bed unit consists of a pair of tubes in series containing ion exchange resins, which remove organic acids from the catalytic reactor effluent, and microbial check valve resin, which injects iodine into the water as a biocide agent. This unit is returning for repair and re-flight.
Catalytic Oxidizer – Allows the trace containment control system to remove molecular contaminants from in-orbit atmosphere. This item is returning for repair and re-flight.
Urine Processor Assembly Pressure Control and Pump Assembly – This multi-tube purge pump enables the removal of non-condensable gas and water vapor from the distillation assembly within the greater urine processing assembly subsystem. This unit is returning to the ground for repair and refurbishment in support of the legacy environmental control and life support system fleet.
Potable Water Dispenser Filter – The filter unit, installed into the potable water dispenser on the station, will provide the capability to remove iodine from the water before the crew consumes it in food and drink packages. This unit will return and be refurbished for re-flight.
Watch and Engage
NASA’s live launch coverage will begin at 9:10 p.m. Nov. 4, and stream on NASA+ and the agency’s website. Live coverage of arrival will begin at 8:45 a.m. Nov. 5, and stream on NASA+ and the agency’s website.
For additional information on the mission, visit: